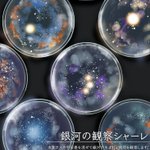

うぃおあと読みます。実験器具×宇宙や季節をモチーフにしたイラスト。ちょっとSF。連絡先*wi0a.stardustlabo0123■gmail.com【Not repost】
- 110 following
- 170 followers
- Follow
This page is posted using the API in accordance with "Twitter Terms of Service". Learn more.
約32 件
正しいカテゴリを運営へ報告する
このツイートに主として含まれるのは、【***】ではなく、以下の画像です。
- 一般向けのイラストおよびマンガ。造形物に描かれた平面のイラスト等もここに含みます。
- コスチューム・プレイ(仮装)をした人物の写真。衣装のみの写真も含む。
- 立体造形物全般。模型・フィギュア・プラモデル・ドール・ぬいぐるみ・キャラ弁・ハンドクラフト等
- 【イラスト・マンガ】のうち、センシティブな内容(アダルト表現・グロテスク表現)を含むもの。
- 風景写真・ゲームやTVのキャプチャ・スクリーンショット・文字のみの画像等、上記にあてはまらないもの。

This site is protected by reCAPTCHA and the GooglePrivacy Policy and Terms of Service apply.
正しいカテゴリを運営へ報告する
報告ありがとうございました!
内容を確認のうえ、対応いたします。